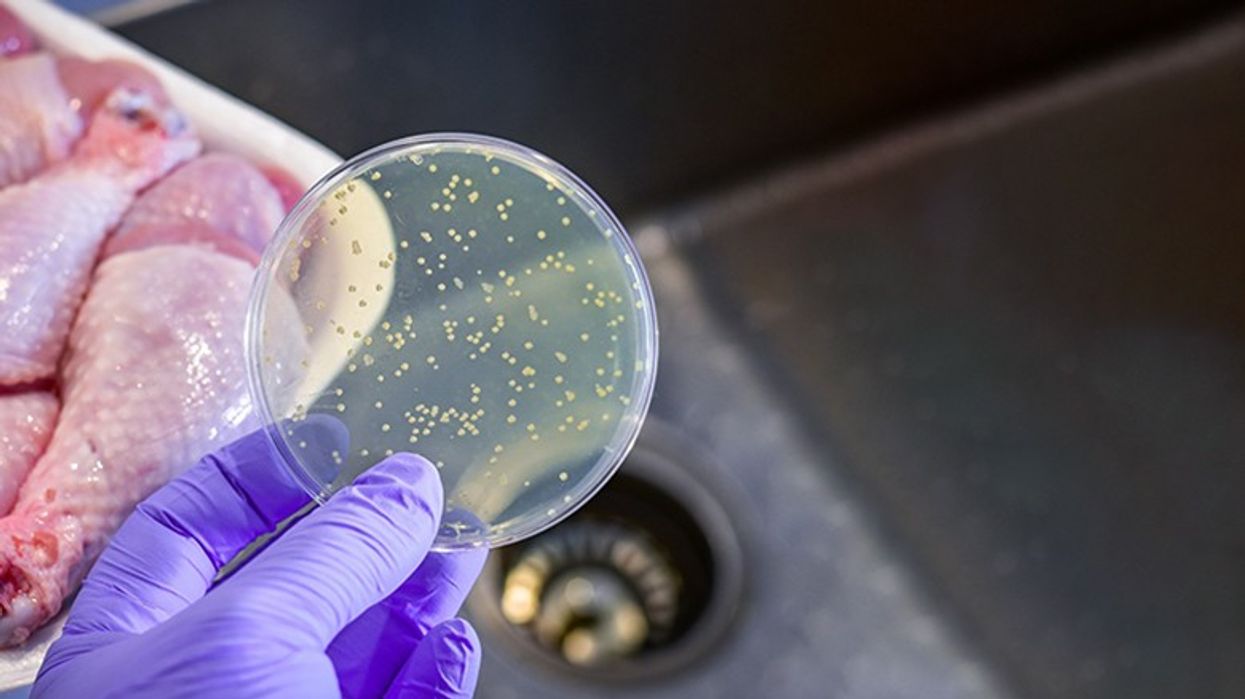
2018/01/food_borne_illness_1200.jpg

Mishi i pulës ka më së shumti lloje të E. Coli
Për shkak të numrit të madh të antibiotikëve me të cilat trajtohen pulat, në to zhvillohet një lloj rezistent i bakterit Escherichia coli, i cili në organizëm hyn me ngrënien e mishit dhe shkakton infeksione të dhimbshme.
Shkencëtarët për një kohë të gjatë kanë besuar që infeksionet e dhimbshme urinare të cilat çdo ditë prekin miliona femra në botë vijnë nga vetë zorrët e njerëzve, por analiza e mostrave të mishit në treg ka treguar të kundërtën, transmeton Telegrafi.
Shkencëtarët kanë analizuar disa lloje të ndryshme të mishit, nga ai i pulës, derrit dhe lopës dhe kanë vërtetuar që në mishin e pulës ka më së shumti lloje Escherichia coli rezistent në antibiotikë, ndërsa ato baktere nuk hyjnë në organizimin njerëzor gjatë përgatitjes së ushqimit, por vetëm me ngrënien e mishit i cili përmban baktere.
Supozohet që pula ka më së shumti E.Coli për shkak të sasisë së madhe të antibiotikëve me të cilat ushqehen zogjtë e pulës, që të rritet prodhimtaria dhe rendimenti i tyre.
Për fat të keq nuk ka kurë specifike, terapia me antibiotikë, ashtu si me gastroenteritet nuk është efikase, madje mund të përkeqësojë situatën.
Prandaj mjekëve nuk u mbetet tjetër veç mundësisë për të zbutur simptomat. Në këtë mes ndihmojnë infuzionet, të cilat kompensojnë humbjen e lëngjeve te pacientët, te pacientët me simptoma të rënda, pastrimi i gjakut përmes dializës mund të parandalojë dëmtimin e përhershëm të veshkave.
Escherichia coli është njëra ndër bakteret më të rënda. Gjëja kryesore në trajtimin e këtyre bakterieve është që të bëjë që ju të ruani rehatinë dhe të parandaloni përhapjen e saj. /Telegrafi/

















































